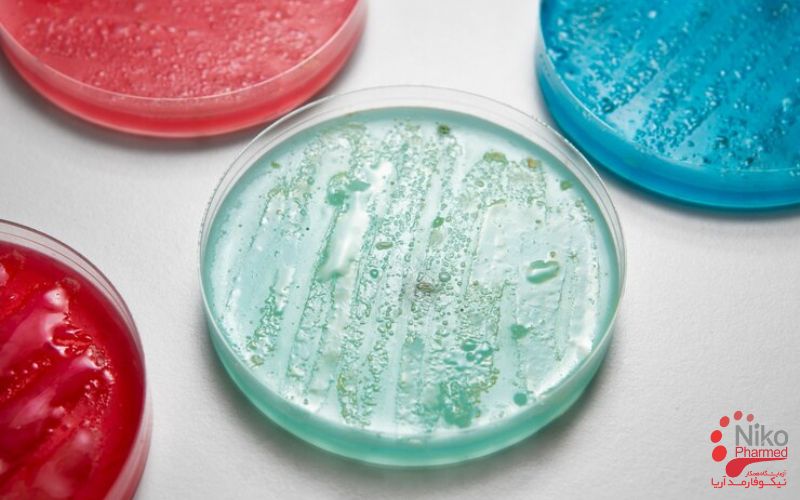
antibacterial testing

What is Antibacterial Testing?
Antibacterial testing is a standardized microbiological procedure used to assess the ability of a substance to inhibit or kill bacterial pathogens.It plays a critical role in microbiology, pharmaceutical development, and public health by determining whether a material or compound possesses antimicrobial activity against specific bacterial strains. This testing helps identify potential therapeutic agents, assess product safety, and monitor resistance patterns. With the global rise of antibiotic-resistant bacteria—such as methicillin-resistant Staphylococcus aureus (MRSA) and multidrug-resistant Escherichia coli—antibacterial testing has become increasingly vital. In addition to qualitative screening, we provide quantitative MIC/MBC testing to determine the minimum inhibitory and bactericidal concentrations of antibacterial agents
Types of Antibacterial Testing
Bactericidal Activity of Disinfectants
The bactericidal activity of disinfectants is quantitatively assessed using standardized methods such as EN 1276 and ASTM E2315, both of which evaluate a disinfectant’s ability to kill bacteria in suspension under simulated use conditions.
EN 1276 is a European standard that requires a ≥5 log₁₀ (99.999%) reduction in viable bacterial count within a specified contact time (usually 5 minutes or less) when tested against standard strains such as Escherichia coli, Staphylococcus aureus, Pseudomonas aeruginosa, and Enterococcus hirae.
Similarly, ASTM E2315, an American standard, measures the time-kill kinetics of liquid antimicrobials over short exposure periods (typically 15 seconds to 1 minute). In both methods, a high concentration of the test microorganism is mixed with the disinfectant, incubated for the specified contact time, then neutralized using a validated quenching agent to stop antimicrobial activity.
The surviving bacteria are recovered and quantified using serial dilution and plate counting. The log reduction in bacterial population, compared to a non-treated control, determines the disinfectant’s efficacy. These methods are crucial for validating surface and liquid disinfectants used in healthcare, food production, and public sanitation, ensuring they achieve rapid and effective microbial kill under real-world conditions.
Antibacterial Activity of Plastics
The antibacterial activity of plastics is evaluated using the standardized method ISO 22196:2011, titled “Measurement of antibacterial activity on plastics and other non-porous surfaces”. This test is designed to quantitatively assess the ability of treated plastic surfaces to inhibit the growth of specific bacteria under controlled conditions.
The procedure involves inoculating a defined concentration of bacterial suspension—commonly Staphylococcus aureus (ATCC 6538) and Escherichia coli (ATCC 8739)—onto both untreated (control) and treated test specimens.
A sterile film is placed over the inoculum to ensure even contact and prevent evaporation. Samples are incubated at 35 ± 1 °C and ≥90% relative humidity for 24 hours. After incubation, the bacteria are recovered and enumerated using serial dilution and plate count methods.
The antibacterial activity is calculated by comparing the bacterial counts between the treated and untreated surfaces, expressed as a log reduction value (R). An R value ≥2.0 indicates significant antibacterial activity (i.e., ≥99% reduction in bacterial population).
ISO 22196 provides a reproducible framework for manufacturers to validate the efficacy of antibacterial treatments on plastic materials used in healthcare, consumer goods, and industrial applications.
Antibacterial Activity of Textile Products
The antibacterial activity of textile products is assessed using the international standard ISO 20743:2013, titled “Textiles — Determination of antibacterial activity of textile products”. This method quantitatively measures the ability of treated or untreated textile materials to inhibit the growth of bacteria under specified conditions.
The test typically uses bacterial strains such as Staphylococcus aureus (ATCC 6538) and Klebsiella pneumoniae (ATCC 4352). ISO 20743 includes several test methods—most notably the absorption method, transfer method, and printing method—chosen based on the type and intended use of the fabric.
In the commonly used absorption method, a known volume of bacterial suspension is inoculated directly onto the fabric samples, which are then incubated at 37 ± 1 °C for 18–24 hours under controlled humidity. After incubation, bacteria are extracted from the textiles and quantified using plate count techniques.
The antibacterial activity is expressed as the difference in bacterial count (log reduction) between the test specimen and an untreated control. A reduction of ≥2.0 log (≥99% bacterial reduction) is generally considered significant. ISO 20743 is widely used in evaluating antimicrobial textiles for healthcare, hygiene, and consumer applications.
Antimicrobial Efficacy of Hand Hygiene Products
The antimicrobial efficacy of hand hygiene products—including hand sanitizers and antimicrobial soaps—is evaluated using standardized methods such as ASTM E2755 and ASTM E1174, both of which assess the reduction of transient bacteria on human skin under controlled conditions.
ASTM E1174 is primarily used to evaluate antimicrobial hand washes (e.g., soaps), while ASTM E2755 is optimized for leave-on hand rubs like alcohol-based hand sanitizers.
In both methods, healthy human volunteers’ hands are artificially contaminated with a standardized inoculum of Serratia marcescens (a nonpathogenic indicator organism), followed by application of the test product according to a defined protocol (e.g., volume, duration of rubbing, rinsing if applicable).
Samples are collected from the hands pre- and post-treatment using a glove juice sampling method, in which the hands are placed in sterile gloves filled with neutralizing solution and massaged to recover surviving bacteria.
The number of viable bacteria is then determined using plate count methods. The log reduction in bacterial count indicates the product’s efficacy. According to U.S. FDA guidelines, a ≥2 log₁₀ reduction after the first application and ≥3 log₁₀ after the tenth application are expected benchmarks for antimicrobial hand washes. These ASTM methods are critical for demonstrating the real-world effectiveness of hand hygiene formulations in reducing the transmission of infectious agents.
Bactericidal Activity of Disinfectants
The bactericidal activity of disinfectants is quantitatively assessed using standardized methods such as EN 1276 and ASTM E2315, both of which evaluate a disinfectant’s ability to kill bacteria in suspension under simulated use conditions. EN 1276 is a European standard that requires a ≥5 log₁₀ (99.999%) reduction in viable bacterial count within a specified contact time (usually 5 minutes or less) when tested against standard strains such as Escherichia coli, Staphylococcus aureus, Pseudomonas aeruginosa, and Enterococcus hirae.
Similarly, ASTM E2315, an American standard, measures the time-kill kinetics of liquid antimicrobials over short exposure periods (typically 15 seconds to 1 minute). In both methods, a high concentration of the test microorganism is mixed with the disinfectant, incubated for the specified contact time, then neutralized using a validated quenching agent to stop antimicrobial activity.
The surviving bacteria are recovered and quantified using serial dilution and plate counting. The log reduction in bacterial population, compared to a non-treated control, determines the disinfectant’s efficacy. These methods are crucial for validating surface and liquid disinfectants used in healthcare, food production, and public sanitation, ensuring they achieve rapid and effective microbial kill under real-world conditions.
Antimicrobial Efficacy of UVGI Devices
The antimicrobial efficacy of UVGI (Ultraviolet Germicidal Irradiation) devices is evaluated using standardized methods such as ASTM E3135 and ISO 15714, which provide protocols for assessing the reduction of viable microorganisms following exposure to germicidal UV-C radiation.
ASTM E3135 outlines a test method to determine the efficacy of UV devices in inactivating microorganisms on surfaces or in air, typically using indicator organisms like Staphylococcus aureus or Escherichia coli.
In this procedure, known concentrations of test bacteria are applied to standardized carriers (e.g., stainless steel or glass), which are then exposed to a specified dose of UV-C light (usually at 254 nm) for defined exposure times and distances. After irradiation, microorganisms are recovered from the carriers using neutralizing media and quantified using standard plate count techniques.
ISO 15714 provides a broader framework for evaluating the effectiveness of UVGI systems for air disinfection, incorporating parameters such as airflow rate, UV dose, and microorganism resistance. The antimicrobial efficacy is expressed as log₁₀ reduction in viable counts compared to non-irradiated controls.
These methods are essential for validating the performance of UVGI systems in healthcare, laboratory, HVAC, and public settings to ensure they deliver effective microbial inactivation under defined operating conditions.
Great. I’ll prepare a detailed and professionally tailored write-up promoting Nikopharmad’s capabilities in a wide range of antibacterial testing services. This will include references to applicable international standards (e.g., ISO 22196, ISO 20743, EN 1276, ASTM E2755), lab credentials, and advantages such as scientific expertise, regulatory compliance, and data protection.
Why Choose Nikopharmad for Your Antibacterial Testing Needs?
ILAC Accreditation & ISO/IEC 17025 Certification
Nikopharmad Laboratory holds full accreditation under the ILAC Mutual Recognition Arrangement and is certified to ISO/IEC 17025 standards. These credentials ensure that our antibacterial testing services meet internationally accepted benchmarks for analytical accuracy, reproducibility, and technical rigor. As an ILAC-recognized lab, our test results carry global trust and are accepted across borders without the need for redundant testing.
Comprehensive Antibacterial Testing Services
Nikopharmad offers a full suite of validated antibacterial testing services based on gold-standard methodologies from CLSI، EUCAST and ISO guidelines.
Expert Scientific Staff & Advanced Laboratory Infrastructure
Our antibacterial testing services are led by a team of highly qualified microbiologists, biochemists, and pharmaceutical scientists. They bring extensive expertise in antibiotic susceptibility testing, resistance profiling, and custom method development, ensuring that every assay is performed to the highest scientific standards.
Nikopharmed is equipped with state-of-the-art microbiology instrumentation and operates under strict quality control protocols. This advanced infrastructure enables us to handle complex testing requirements with precision and high throughput, so you can trust the reliability of our results even for your most challenging samples.
Accelerated Timelines with Validated Methodologies
We understand that timely results are critical for decision-making in product development and clinical research. Our validated antibacterial testing methods are optimized for speed without sacrificing accuracy, enabling us to provide rapid turnaround results.
Nikopharmad’s accelerated timelines help you meet project milestones faster while still generating high-quality data to inform your next steps.
Competitive & Transparent Pricing
Nikopharmad is committed to providing high-quality antibacterial testing at competitive rates. Our pricing structure is transparent and flexible: we offer customizable service packages, volume-based discounts for larger testing projects, and long-term engagement models for ongoing partnerships.
Whether you’re an early-stage biotech startup or an established pharmaceutical manufacturer, our solutions can be tailored to fit your budget and scale of work—without ever compromising on quality or compliance.
Data Security & Intellectual Property Protection
Protecting your data and intellectual property is our highest priority. We enforce strict confidentiality through binding NDAs (Non-Disclosure Agreements) and robust data security protocols to safeguard your sensitive information. All test results and records are managed in secure electronic systems compliant with FDA 21 CFR Part 11 requirements for electronic records, as well as GxP data integrity standards.
Our audit-ready documentation practices ensure that every data point is traceable and protected, giving you peace of mind that your formulations and results remain confidential and secure.
Regulatory Compliance & Global Submission Support
Our antibacterial testing reports are prepared to meet stringent regulatory and quality guidelines, making them suitable for submissions worldwide. We align our methodologies and documentation with internationally recognized standards – including CLSI and EUCAST recommendations, ISO 20776 for susceptibility testing, and ICH (International Council for Harmonisation) guidelines – to ensure acceptance by global health authorities. Each report includes comprehensive details of the study and findings, such as:
- Methodology and Protocols: Detailed descriptions of the test methods and controls used
- Validation & Quality Control: Validation data and QC results demonstrating the accuracy and reliability of the assays
- Interpretive Criteria: Clear criteria for interpreting results (for example, whether an organism’s response indicates a bacteriostatic vs. bactericidal effect)
This thorough documentation provides regulators with the information they need and streamlines your submission process. With Nikopharmad’s reports, you can confidently support your claims about an antibacterial product’s efficacy and safety in any regulatory jurisdiction.
To request testing or a complimentary consultation contact Nikopharmad
Partner with Nikopharmad for Accurate, Compliant, and Cost-Effective Antibacterial Testing
By choosing Nikopharmad for your antibacterial testing needs, you gain a trusted laboratory partner with proven scientific expertise, rapid turnaround times, regulatory-grade quality systems, and budget-friendly services. Our precise antibacterial susceptibility profiling ensures that your products and active ingredients are evaluated with the highest level of scientific rigor – yielding reliable data for confident decision-making. With Nikopharmad’s support, you will be well-equipped to advance your antibacterial product through R&D and regulatory approval, backed by accurate results and comprehensive compliance.